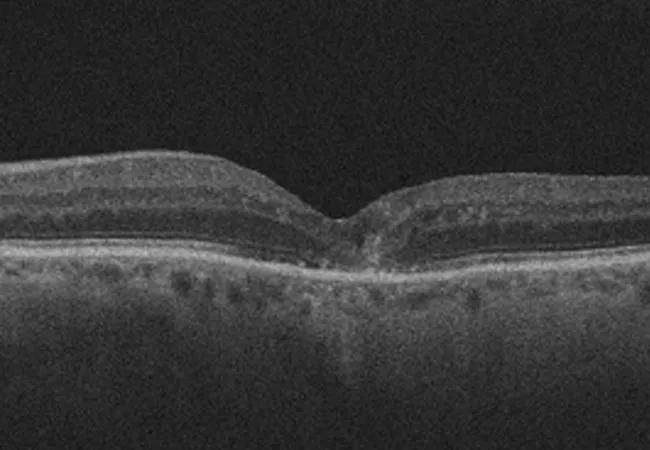

Studies evaluate patients who missed treatments for diabetic macular edema and neovascular age-related macular degeneration
Image content: This image is available to view online.
View image online (https://assets.clevelandclinic.org/transform/6ca4839b-4629-464d-b3a0-2244fd92a052/20-EYE-1964900-Lapse-in-AMD-and-DME-treatment-Hero_jpg)
20-EYE-1964900-Lapse-in-AMD-and-DME-treatment-Hero
By Thais F. Conti, MD, and Rishi P. Singh, MD
Advertisement
Cleveland Clinic is a non-profit academic medical center. Advertising on our site helps support our mission. We do not endorse non-Cleveland Clinic products or services. Policy
Diabetic retinopathy and age-related macular degeneration (AMD) are leading causes of visual impairment. Diabetic retinopathy is a microvasculopathy that occurs as a long-standing complication of poorly controlled diabetes mellitus. Vascular endothelial growth factor (VEGF), released as a result of inflammation and oxidative stress in diabetic retinopathy, is believed to drive the process of vascular proliferation, resulting in proliferative diabetic retinopathy and diabetic macular edema (DME). Neovascular AMD (nAMD) is one of the most severe manifestations of AMD, which is characterized by the growth of disordered and poorly formed blood vessels that cause complications such as exudation of fluid into retinal tissue.
Previously published clinical studies show that VEGF inhibitors (such as aflibercept, bevacizumab and ranibizumab) decrease the rate of disease progression in patients with DME and nAMD. However, the short treatment interval required for patients sometimes can impose a significant treatment burden. Additionally, in routine clinical practice many factors (such as age, comorbidities, the perceived unpleasantness of intraocular injections, general access issues and insurance coverage) can contribute to compliance challenges and increase rates of treatment interruption and loss to follow-up (LTFU).
Understanding how LTFU affects patients with DME and AMD is even more important now, after the recent outbreak of COVID-19. The pandemic placed enormous strain on U.S. health systems, resulting in a significant decrease in outpatient activities, with thousands of appointments canceled or rescheduled.
Advertisement
To better characterize the anatomic outcomes and visual acuity changes of patients who experience unintended lapses in care of DME and nAMD, Cleveland Clinic’s Center for Ophthalmic Bioinformatics conducted two retrospective studies.
Patients who experienced a lapse in care of three months or more that was not consistent with provider recommendation (e.g., treat-and-extend protocol or pro re nata [PRN] regimen) were included in the studies as a lapse group. Variables were collected from the visit date preceding their lapse in care (baseline), the visit date immediately following the lapse (post-lapse), and at follow-up visits at three, six and 12 months.
In the DME study, the average treatment lapse was 6.2 ± 3.5 months (a range of three to 24 months). Findings indicated that a single unintended, relatively short lapse in anti-VEGF treatment did not have significant anatomic consequences upon resumption of regular treatment and follow-up. There were no significant differences between lapse and control groups in central subfield thickness or visual acuity at the post-lapse appointment. Additional analysis at months after lapse also did not find significant differences.
In the nAMD study, the average treatment lapse was 5.0 ± 3.7 months. In contrast to the DME study, nAMD patients in the lapse group experienced significant increases in central subfield thickness that normalized upon resumption of treatment, as well as concordant decreases in visual acuity that trended downward over time despite the normalization of central subfield thickness. Visual acuity in the lapse group was significantly lower when compared to the control group at all time points following the lapse (-6.62 letters at post-lapse [P < 0.01], -6.59 letters at three months [P < 0.01], -6.16 letters at six months [P < 0.01] and -5.46 letters at 12 months [P < 0.01]). In contrast, the control group’s central subfield thickness and visual acuity remained relatively constant throughout the study period.
Advertisement

Image content: This image is available to view online.
View image online (https://assets.clevelandclinic.org/transform/38b189ee-1568-476d-8c3e-29dae4f3d45b/20-EYE-1964900-Lapse-in-AMD-and-DME-treatment-Inset-1_jpg)
OCT images of a patient with neovascular age-related macular degeneration at baseline (A),
post-lapse (B) and 12 months after restarting anti-VEGF treatment (C). OCT images of a patient with diabetic macular edema at baseline (D), post-lapse (E) and 12 months after
restarting anti-VEGF treatment (F).
These findings demonstrate that, despite the efficacy of anti-VEGF treatment in resolving gross anatomical derangements, the damage done to the retina on a cellular level and the deterioration of visual acuity after a lapse may, in many instances, be irreversible and is dependent on the disease being treated. Taken together, information from these studies informs providers of the visual loss that can occur with lapses and allows providers to better counsel patients on the consequences of LTFU.
Dr. Conti is a research fellow in the Center for Ophthalmic Bioinformatics at Cleveland Clinic’s Cole Eye Institute. Dr. Singh is a staff surgeon at Cole Eye Institute and Medical Director of Informatics at Cleveland Clinic.
Advertisement
Advertisement
The drug does not provide lasting disease control for most patients
New service for patients with diabetes will make annual screening more convenient
Gonioscopy can help determine next steps in reducing IOP
Similarly, patients with noninfectious uveitis have a higher risk of being diagnosed with an autoimmune disease within five years
A review of pathophysiology, risk factors, clinical presentation and treatment options
How computational tools and personalized biomechanics can improve keratoconus detection, ectasia risk assessment and surgical outcomes
Motion-tracking Brillouin microscopy pinpoints corneal weakness in the anterior stroma
Registry data highlight visual gains in patients with legal blindness